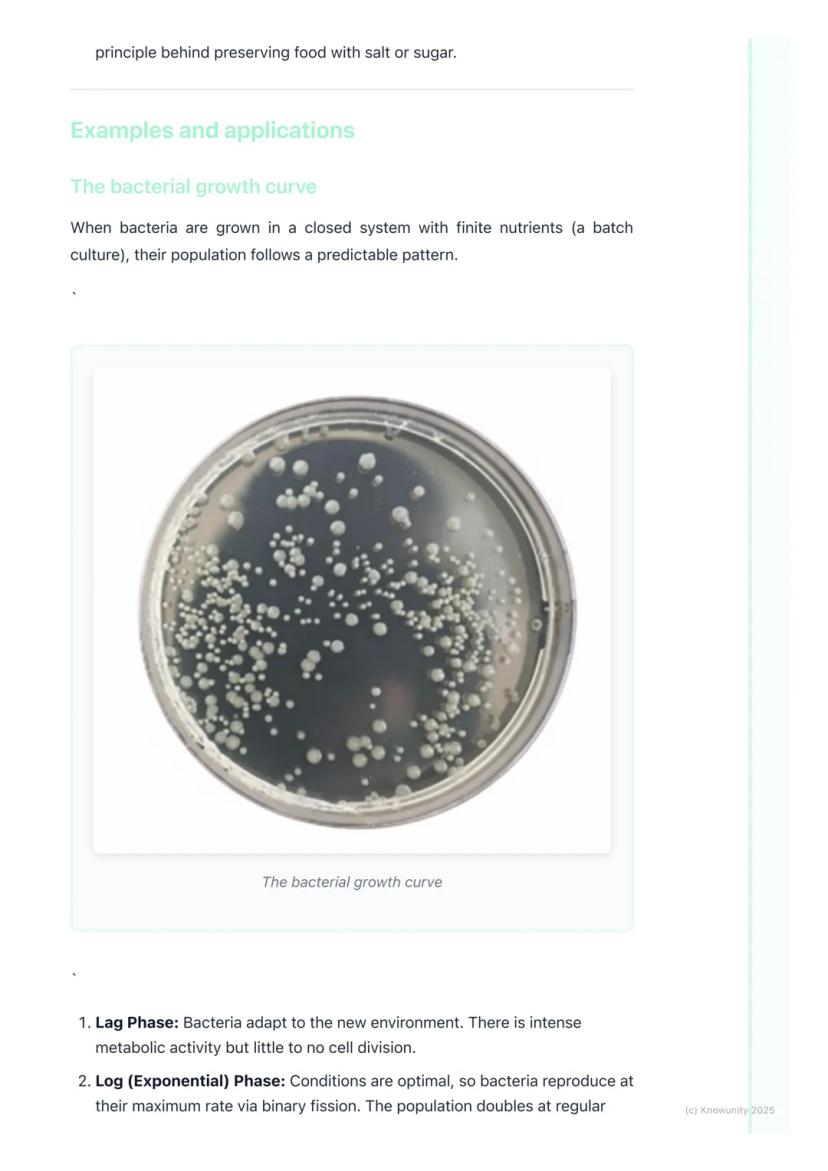
Page 5

Ever wondered what makes you sick or helps make your...
Understanding Bacteria: Structure, Growth, and Their Role in Life








Introduction to Bacteria
You're surrounded by billions of bacteria right now, and that's actually a good thing! Bacteria are prokaryotic organisms, which means their DNA floats freely in the cell rather than being locked away in a nucleus like ours is.
These microscopic powerhouses are found absolutely everywhere - in soil, water, inside your gut, and even in extreme environments like hot springs. Don't worry though, most bacteria are either harmless or actually helpful to us.
Understanding bacteria is essential for your exams because they're involved in so many biological processes. From making food to causing infections, bacteria are key players you need to know about.
Quick Tip: Remember that prokaryotic = no nucleus. This is a classic exam comparison question between bacterial and human cells!

Bacterial Structure
Think of a bacterial cell as a simple but efficient machine. You'll need to draw and label this structure in your exams, so let's break down each part and what it does.
The cell wall made of peptidoglycan is like the bacterium's armour - it prevents the cell from bursting and gives it shape. Inside, the cytoplasm is where all the chemical reactions happen, whilst 70S ribosomes (smaller than ours) make proteins.
The nucleoid contains the main circular chromosome, whilst plasmids are like bonus DNA circles that often carry useful genes like antibiotic resistance. Some bacteria also have a flagellum for swimming around and a capsule for extra protection.
Exam Alert: The differences between prokaryotic and eukaryotic cells (no nucleus, 70S vs 80S ribosomes, peptidoglycan cell walls) are exam favourites!

Bacterial Shapes and Reproduction
Bacteria come in three basic shapes that you need to recognise. Cocci are spherical (like Staphylococcus aureus that causes skin infections), bacilli are rod-shaped (like E. coli in your gut), and spirilla are spiral-shaped.
Binary fission is how bacteria reproduce - it's much simpler than the mitosis you've studied. The bacterial DNA copies itself, moves to opposite ends of the cell, and then the cell simply splits in two. Job done!
This process is incredibly fast under the right conditions. Because it produces identical clones, any genetic variation in bacteria comes from mutations or when they swap plasmids with each other.
Don't Confuse: Binary fission (simple bacterial reproduction) is completely different from mitosis (complex eukaryotic cell division).

Bacterial Nutrition and Growth Requirements
Bacteria are incredibly diverse in how they get their energy and food. Photoautotrophs use sunlight like plants do, whilst chemoautotrophs get energy from chemicals like ammonia. Saprophytes are the recyclers - they break down dead organic matter.
Parasitic bacteria are the troublemakers that cause disease by living off their hosts. Different bacteria also have varying oxygen needs - some require it, others are killed by it, and some can take it or leave it.
Several factors affect how quickly bacteria grow: temperature, pH, oxygen levels, and nutrient availability. High salt or sugar concentrations can actually preserve food by stopping bacterial growth through osmosis.
Food for Thought: The principle behind preserving food with salt or sugar is that it dehydrates bacteria, stopping their growth!

The Bacterial Growth Curve
When bacteria are grown in a lab with limited nutrients, their population follows a predictable pattern that you need to understand for exams.
The lag phase is like bacteria getting settled in - lots of metabolic activity but no reproduction yet. Then comes the log phase where conditions are perfect and the population doubles at regular intervals through rapid binary fission.
The stationary phase occurs when growth rate equals death rate due to nutrient depletion and waste build-up. Finally, the decline phase sees more bacteria dying than being born as conditions become increasingly harsh.
Exam Tip: Be ready to explain why each phase occurs - stationary phase happens because nutrients run out and toxic waste accumulates!

Importance of Bacteria
Bacteria are both heroes and villains in our world. On the good side, Lactobacillus makes your yoghurt and cheese, genetically modified E. coli produce insulin for diabetics, and nitrogen-fixing bacteria help plants grow by converting atmospheric nitrogen.
Your gut bacteria are particularly important - they make vitamins like Vitamin K and help prevent harmful bacteria from taking over. Without bacteria, nutrient cycling would stop and life on Earth would collapse.
However, pathogenic bacteria cause serious diseases like tuberculosis, strep throat, and food poisoning. They also cause food spoilage, which is why we need preservation methods.
Remember: Bacteria are essential for life on Earth - they're not all bad guys trying to make you sick!

Antibiotics and Resistance
Antibiotics are substances that kill bacteria or stop their growth by targeting structures unique to bacteria, like their peptidoglycan cell walls or 70S ribosomes. Crucially, they don't work against viruses because viruses lack these targets.
Antibiotic resistance is one of the biggest health crises facing us today. Here's how it develops: a random mutation might make one bacterium resistant to an antibiotic. When the antibiotic is used, it kills all the non-resistant bacteria but the resistant one survives and reproduces.
This is natural selection in action - the resistant strain becomes dominant and can pass resistance genes to other bacteria through plasmids. Misuse of antibiotics, like not finishing prescribed courses, makes this problem worse.
Critical Point: Antibiotic resistance demonstrates natural selection perfectly - it's a guaranteed exam topic you need to understand thoroughly!
Νομίζαμε ότι δε θα ρωτούσες ποτέ...
Τι είναι ο AI σύντροφος του Knowunity;
Ο AI σύντροφός μας είναι ειδικά σχεδιασμένος για τις ανάγκες των μαθητών. Βασισμένοι στα εκατομμύρια κομμάτια Περιεχομένων που έχουμε στην πλατφόρμα, μπορούμε να παρέχουμε πραγματικά ουσιαστικές και σχετικές απαντήσεις στους μαθητές. Αλλά δεν αφορά μόνο τις απαντήσεις, ο σύντροφος είναι ακόμη περισσότερο για την καθοδήγηση των μαθητών στις καθημερινές τους μαθησιακές προκλήσεις, με εξατομικευμένα προγράμματα μελέτης, κουίζ ή Περιεχόμενα στη Συνομιλία και 100% εξατομίκευση βασισμένη στις δεξιότητες και την ανάπτυξη των μαθητών.
Πού μπορώ να κατεβάσω την εφαρμογή Knowunity;
Μπορείτε να κατεβάσετε την εφαρμογή από το Google Play Store και το Apple App Store.
Πώς μπορώ να λάβω την πληρωμή μου; Πόσα μπορώ να κερδίσω;
Ναι, έχετε δωρεάν πρόσβαση στο περιεχόμενο της εφαρμογής και στον AI companion μας. Για να ξεκλειδώσετε ορισμένες λειτουργίες της εφαρμογής, μπορείτε να αγοράσετε το Knowunity Pro.
Πιο δημοφιλή περιεχόμενα στο Biology
8Ecology introduction notes!
Start of the leaving cert ecology chapter
DNA & RNA
All notes on DNA & RNA including protein synthesis which is a HL topic
Vertebrates and Invertebrates
Students will distinguish between animals that have a backbone (vertebrates) and those that do not (invertebrates), identifying examples of each.
Biomolecules: chapter 8
Summary and easily understandable notes to revise chapter 8 biomolecules. Includes good labelled diagrams for visual learners
Circulatory System
Students will learn about the heart, blood, and blood vessels, and how this system transports oxygen, nutrients, and waste products around the body.
Respiration
All respiration notes including simple diagrams and glycolysis and the Krebs cycle
Photosynthesis : Biology
Photosynthesis
Plant Cells
Learning about the unique structures found in plant cells, such as the cell wall, chloroplasts, and large vacuole, and how they differ from animal cells.
Πιο δημοφιλή περιεχόμενα
9Irish oral questions and answers
Questions and answers for the leaving cert oral
Key Quotes : Sive
Key Quotes and explanations: Sive
Irish oral questions
Outline of oral questions
Iníon- le hÁine Durkin
Aine Durkin’s poem, Iníon: Themes & summary
Irish poetry 2027
Iníon + Dínit an Bhróin
LC HL notes- Iníon (poem)
Includes poem in English and Irish, theme, key words & phrases
Cultural Context : Shawshank Redemption : Sive : Small Things Like These
Comparative Study : Cultural Context : Shawshank Redemption, Sive and Small Things Like These
Mo Ghrá-sa (Idir Lúibíní)
Notes on mo ghrá-sa
An Gaeilge Aiste
Irish Language essay
Δε μπορείς να βρεις αυτό που ψάχνεις; Εξερεύνησε άλλα μαθήματα.
Κριτικές από τους χρήστες μας. Έχουν όλα τα καλά — και το ίδιο θα είχες κι εσύ.
Η εφαρμογή είναι πολύ εύκολη στη χρήση και καλά σχεδιασμένη. Έχω βρει ό,τι έψαχνα μέχρι τώρα και έχω μάθει πολλά από τις παρουσιάσεις! Σίγουρα θα χρησιμοποιήσω την εφαρμογή για μια εργασία του μαθήματος! Και φυσικά βοηθάει πολύ και ως έμπνευση.
Αυτή η εφαρμογή είναι πραγματικά τέλεια. Υπάρχουν τόσες πολλές σημειώσεις μελέτης και βοήθεια [...]. Το μάθημα που με δυσκολεύει είναι τα Γαλλικά, για παράδειγμα, και η εφαρμογή έχει τόσες επιλογές για βοήθεια. Χάρη σε αυτή την εφαρμογή, έχω βελτιώσει τα Γαλλικά μου. Θα την πρότεινα σε οποιονδήποτε.
Ουάου, είμαι πραγματικά εντυπωσιασμένος. Δοκίμασα την εφαρμογή επειδή την είδα διαφημισμένη πολλές φορές και έμεινα άφωνος. Αυτή η εφαρμογή είναι Η ΒΟΗΘΕΙΑ που χρειάζεσαι για το σχολείο και πάνω απ' όλα, προσφέρει τόσα πράγματα, όπως ασκήσεις και φύλλα γεγονότων, που ήταν ΠΟΛΥ χρήσιμα για μένα προσωπικά.
Understanding Bacteria: Structure, Growth, and Their Role in Life
Ever wondered what makes you sick or helps make your yoghurt? Bacteria are everywhere - literally! These tiny single-celled organisms are some of the most important life forms on Earth, playing crucial roles in everything from keeping you healthy to...

Introduction to Bacteria
You're surrounded by billions of bacteria right now, and that's actually a good thing! Bacteria are prokaryotic organisms, which means their DNA floats freely in the cell rather than being locked away in a nucleus like ours is.
These microscopic powerhouses are found absolutely everywhere - in soil, water, inside your gut, and even in extreme environments like hot springs. Don't worry though, most bacteria are either harmless or actually helpful to us.
Understanding bacteria is essential for your exams because they're involved in so many biological processes. From making food to causing infections, bacteria are key players you need to know about.
Quick Tip: Remember that prokaryotic = no nucleus. This is a classic exam comparison question between bacterial and human cells!

Bacterial Structure
Think of a bacterial cell as a simple but efficient machine. You'll need to draw and label this structure in your exams, so let's break down each part and what it does.
The cell wall made of peptidoglycan is like the bacterium's armour - it prevents the cell from bursting and gives it shape. Inside, the cytoplasm is where all the chemical reactions happen, whilst 70S ribosomes (smaller than ours) make proteins.
The nucleoid contains the main circular chromosome, whilst plasmids are like bonus DNA circles that often carry useful genes like antibiotic resistance. Some bacteria also have a flagellum for swimming around and a capsule for extra protection.
Exam Alert: The differences between prokaryotic and eukaryotic cells (no nucleus, 70S vs 80S ribosomes, peptidoglycan cell walls) are exam favourites!

Bacterial Shapes and Reproduction
Bacteria come in three basic shapes that you need to recognise. Cocci are spherical (like Staphylococcus aureus that causes skin infections), bacilli are rod-shaped (like E. coli in your gut), and spirilla are spiral-shaped.
Binary fission is how bacteria reproduce - it's much simpler than the mitosis you've studied. The bacterial DNA copies itself, moves to opposite ends of the cell, and then the cell simply splits in two. Job done!
This process is incredibly fast under the right conditions. Because it produces identical clones, any genetic variation in bacteria comes from mutations or when they swap plasmids with each other.
Don't Confuse: Binary fission (simple bacterial reproduction) is completely different from mitosis (complex eukaryotic cell division).

Bacterial Nutrition and Growth Requirements
Bacteria are incredibly diverse in how they get their energy and food. Photoautotrophs use sunlight like plants do, whilst chemoautotrophs get energy from chemicals like ammonia. Saprophytes are the recyclers - they break down dead organic matter.
Parasitic bacteria are the troublemakers that cause disease by living off their hosts. Different bacteria also have varying oxygen needs - some require it, others are killed by it, and some can take it or leave it.
Several factors affect how quickly bacteria grow: temperature, pH, oxygen levels, and nutrient availability. High salt or sugar concentrations can actually preserve food by stopping bacterial growth through osmosis.
Food for Thought: The principle behind preserving food with salt or sugar is that it dehydrates bacteria, stopping their growth!

The Bacterial Growth Curve
When bacteria are grown in a lab with limited nutrients, their population follows a predictable pattern that you need to understand for exams.
The lag phase is like bacteria getting settled in - lots of metabolic activity but no reproduction yet. Then comes the log phase where conditions are perfect and the population doubles at regular intervals through rapid binary fission.
The stationary phase occurs when growth rate equals death rate due to nutrient depletion and waste build-up. Finally, the decline phase sees more bacteria dying than being born as conditions become increasingly harsh.
Exam Tip: Be ready to explain why each phase occurs - stationary phase happens because nutrients run out and toxic waste accumulates!

Importance of Bacteria
Bacteria are both heroes and villains in our world. On the good side, Lactobacillus makes your yoghurt and cheese, genetically modified E. coli produce insulin for diabetics, and nitrogen-fixing bacteria help plants grow by converting atmospheric nitrogen.
Your gut bacteria are particularly important - they make vitamins like Vitamin K and help prevent harmful bacteria from taking over. Without bacteria, nutrient cycling would stop and life on Earth would collapse.
However, pathogenic bacteria cause serious diseases like tuberculosis, strep throat, and food poisoning. They also cause food spoilage, which is why we need preservation methods.
Remember: Bacteria are essential for life on Earth - they're not all bad guys trying to make you sick!
Antibiotics and Resistance
Antibiotics are substances that kill bacteria or stop their growth by targeting structures unique to bacteria, like their peptidoglycan cell walls or 70S ribosomes. Crucially, they don't work against viruses because viruses lack these targets.
Antibiotic resistance is one of the biggest health crises facing us today. Here's how it develops: a random mutation might make one bacterium resistant to an antibiotic. When the antibiotic is used, it kills all the non-resistant bacteria but the resistant one survives and reproduces.
This is natural selection in action - the resistant strain becomes dominant and can pass resistance genes to other bacteria through plasmids. Misuse of antibiotics, like not finishing prescribed courses, makes this problem worse.
Critical Point: Antibiotic resistance demonstrates natural selection perfectly - it's a guaranteed exam topic you need to understand thoroughly!
Νομίζαμε ότι δε θα ρωτούσες ποτέ...
Τι είναι ο AI σύντροφος του Knowunity;
Ο AI σύντροφός μας είναι ειδικά σχεδιασμένος για τις ανάγκες των μαθητών. Βασισμένοι στα εκατομμύρια κομμάτια Περιεχομένων που έχουμε στην πλατφόρμα, μπορούμε να παρέχουμε πραγματικά ουσιαστικές και σχετικές απαντήσεις στους μαθητές. Αλλά δεν αφορά μόνο τις απαντήσεις, ο σύντροφος είναι ακόμη περισσότερο για την καθοδήγηση των μαθητών στις καθημερινές τους μαθησιακές προκλήσεις, με εξατομικευμένα προγράμματα μελέτης, κουίζ ή Περιεχόμενα στη Συνομιλία και 100% εξατομίκευση βασισμένη στις δεξιότητες και την ανάπτυξη των μαθητών.
Πού μπορώ να κατεβάσω την εφαρμογή Knowunity;
Μπορείτε να κατεβάσετε την εφαρμογή από το Google Play Store και το Apple App Store.
Πώς μπορώ να λάβω την πληρωμή μου; Πόσα μπορώ να κερδίσω;
Ναι, έχετε δωρεάν πρόσβαση στο περιεχόμενο της εφαρμογής και στον AI companion μας. Για να ξεκλειδώσετε ορισμένες λειτουργίες της εφαρμογής, μπορείτε να αγοράσετε το Knowunity Pro.
Πιο δημοφιλή περιεχόμενα στο Biology
8Ecology introduction notes!
Start of the leaving cert ecology chapter
DNA & RNA
All notes on DNA & RNA including protein synthesis which is a HL topic
Vertebrates and Invertebrates
Students will distinguish between animals that have a backbone (vertebrates) and those that do not (invertebrates), identifying examples of each.
Biomolecules: chapter 8
Summary and easily understandable notes to revise chapter 8 biomolecules. Includes good labelled diagrams for visual learners
Circulatory System
Students will learn about the heart, blood, and blood vessels, and how this system transports oxygen, nutrients, and waste products around the body.
Respiration
All respiration notes including simple diagrams and glycolysis and the Krebs cycle
Photosynthesis : Biology
Photosynthesis
Plant Cells
Learning about the unique structures found in plant cells, such as the cell wall, chloroplasts, and large vacuole, and how they differ from animal cells.
Πιο δημοφιλή περιεχόμενα
9Irish oral questions and answers
Questions and answers for the leaving cert oral
Key Quotes : Sive
Key Quotes and explanations: Sive
Irish oral questions
Outline of oral questions
Iníon- le hÁine Durkin
Aine Durkin’s poem, Iníon: Themes & summary
Irish poetry 2027
Iníon + Dínit an Bhróin
LC HL notes- Iníon (poem)
Includes poem in English and Irish, theme, key words & phrases
Cultural Context : Shawshank Redemption : Sive : Small Things Like These
Comparative Study : Cultural Context : Shawshank Redemption, Sive and Small Things Like These
Mo Ghrá-sa (Idir Lúibíní)
Notes on mo ghrá-sa
An Gaeilge Aiste
Irish Language essay
Δε μπορείς να βρεις αυτό που ψάχνεις; Εξερεύνησε άλλα μαθήματα.
Κριτικές από τους χρήστες μας. Έχουν όλα τα καλά — και το ίδιο θα είχες κι εσύ.
Η εφαρμογή είναι πολύ εύκολη στη χρήση και καλά σχεδιασμένη. Έχω βρει ό,τι έψαχνα μέχρι τώρα και έχω μάθει πολλά από τις παρουσιάσεις! Σίγουρα θα χρησιμοποιήσω την εφαρμογή για μια εργασία του μαθήματος! Και φυσικά βοηθάει πολύ και ως έμπνευση.
Αυτή η εφαρμογή είναι πραγματικά τέλεια. Υπάρχουν τόσες πολλές σημειώσεις μελέτης και βοήθεια [...]. Το μάθημα που με δυσκολεύει είναι τα Γαλλικά, για παράδειγμα, και η εφαρμογή έχει τόσες επιλογές για βοήθεια. Χάρη σε αυτή την εφαρμογή, έχω βελτιώσει τα Γαλλικά μου. Θα την πρότεινα σε οποιονδήποτε.
Ουάου, είμαι πραγματικά εντυπωσιασμένος. Δοκίμασα την εφαρμογή επειδή την είδα διαφημισμένη πολλές φορές και έμεινα άφωνος. Αυτή η εφαρμογή είναι Η ΒΟΗΘΕΙΑ που χρειάζεσαι για το σχολείο και πάνω απ' όλα, προσφέρει τόσα πράγματα, όπως ασκήσεις και φύλλα γεγονότων, που ήταν ΠΟΛΥ χρήσιμα για μένα προσωπικά.